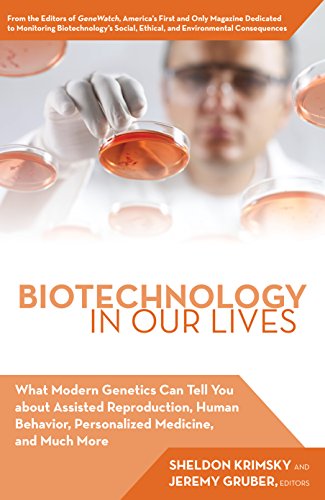
Biotechnology in Our Lives: What Modern Genetics Can Tell You about Assisted Reproduction, Human Behavior, and Personalized Medicine, and Much More

Biotechnology in Our Lives: What Modern Genetics Can Tell You about Assisted Reproduction, Human Behavior, and Personalized Medicine, and Much More Book PDF, ePub eBook
Biotechnology in Our Lives: What Modern Genetics Can Tell You about Assisted Reproduction, Human Behavior, and Personalized Medicine, and Much More.pdf
File Name: Biotechnology in Our Lives: What Modern Genetics Can Tell You about Assisted Reproduction, Human Behavior, and Personalized Medicine, and Much More.pdf
Size: 11.39 MB
Uploaded: 2017-05-4 00:19:13


